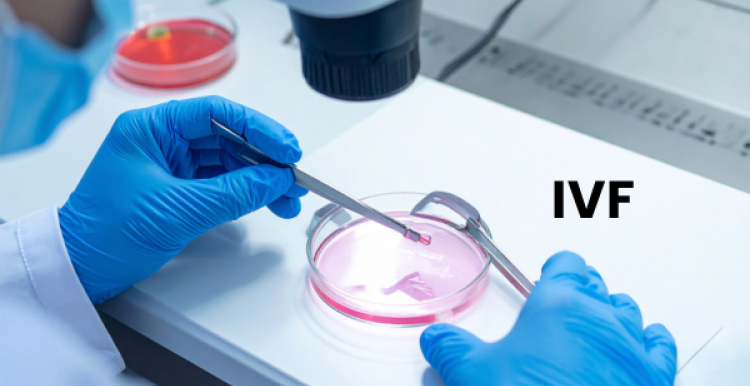
IVF procedure image

Decision on NHS-funded IVF provision in Greater Manchester
From 1st April 2026, a single policy will apply:
- One full IVF cycle for eligible women aged 39 and under.
- A second attempt will be offered only if the first cycle is abandoned or cancelled.
This replaces the current variation between areas, where people are offered between one and three cycles depending on where they live.
How the decision was reached:
The decision follows a six-week public consultation held in June and July 2025. More than 2,200 people took part through surveys and in-person events, including people with direct experience of IVF, residents and health partners.
NHS Greater Manchester recognise that fertility treatment is deeply personal, and that this decision will be upsetting and disappointing for some people. The consultation made clear how emotionally challenging infertility and IVF can be, and they want to acknowledge the strength of feeling, lived experience and personal stories shared with us by those who took part.
There was however, strong support for having the same policy across Greater Manchester. Most respondents said they would prefer two or more IVF cycles rather than one. Concerns raised included the financial impact of reduced NHS-funded provision, particularly for people on lower incomes; the effect on people’s wellbeing and mental health; and the potential impact on some groups, including same-sex couples, people with long-term health conditions and those who may already face barriers to accessing fertility treatment.
The NHS GM Board considered this feedback alongside clinical evidence, current provision across England, and available resources.
Who the policy applies to:
- Anyone referred to an IVF clinic before 1st April 2026 will continue under the current policy.
- Anyone whose referral is received by an IVF clinic on or after 1st April 2026 will be treated under the new policy, regardless of earlier GP or hospital appointments.
It is expected that around 100 women or couples a year will be affected by the change.
What is meant by a “full cycle” and the 1+ approach:
NHS Greater Manchester commissions full IVF cycles, which means all viable embryos from a single egg collection can be used. This gives patients the best possible chance of achieving pregnancy under our 1+ cycle offer.
The 1+ approach covers situations where a cycle cannot be completed:
- Cancelled cycle: treatment may be stopped before egg collection if the cycle isn’t developing as expected.
- Abandoned cycle: eggs are collected but no embryo transfer takes place.
Some first cycles do not progress to embryo transfer. Local data suggests this happens in about 1 in 12 cases, which is why a second attempt is included if the first cycle cannot be completed.
Next steps:
NHS Greater Manchester will work with services and clinics providing IVF to make sure people receive clear information, advice and support as the policy changes.
Further details on the decision are available in the NHS Greater Manchester Integrated Care Board papers from 21st January 2026 (pages 133–270), alongside information about the consultation: 2026-21-01-greater-manchester-integrated-care-board-meeting-papers.pdf.


